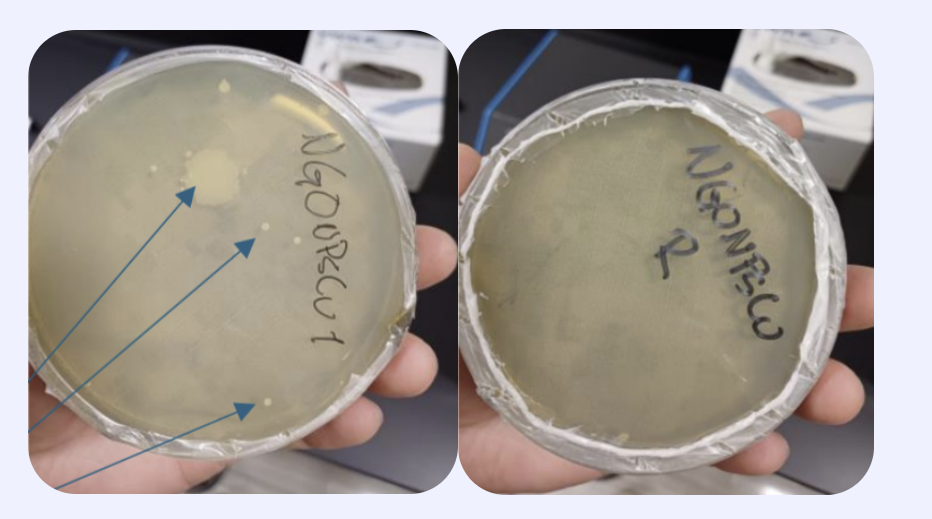
f.jpeg

Improved Coatings and Corrosion Resistance: Graphene and graphene oxide (GO) are being used as additives in automotive paints and coatings to increase durability. A 2022 review by Ford Motor Company researchers noted that low loadings of functionalized graphene (0.25–0.5 wt%) in polyurethane clear-coats enhanced tribological (wear) performance and corrosion resistance of the coating. Likewise, reinforcing conventional polymer paint resins with ~0.3–1% GO or reduced GO has been shown to improve scratch resistance and reduce wear. SeeSpeautomotive. Multiple studies on epoxy-based anti-corrosion paints for steel auto bodies report significant increases in corrosion resistance when even ~0.5–1% graphene or GO is incorporated. These findings (2019–2023) highlight graphene’s role in extending automotive part longevity by imparting superior barrier properties, hardness, and corrosion protection to coatings.
The numerous applications that the automotive industry requires also necessitates different types of graphene. Allkemie can tailor graphene to each application at a fraction of the price that other companies cannot match. Allkemie is already working with industry clients for different solutions in this industry.
Higher-Conductivity Interconnects: Graphene’s exceptional electrical conductivity and strength are being leveraged to improve semiconductor interconnects (the tiny wiring on chips). A recent study in Nano Letters (2024) demonstrated a “graphene-all-around” metallization for nanometer-scale cobalt interconnects, achieving ~10.8% higher current carrying capacity and ~27% lower resistance compared to a standard metal interconnectpubs.acs.org. In a related effort, IBM researchers showed that capping copper interconnect lines with a graphene layer (grown at chip-compatible temperatures) can reduce line resistance by ~5% while greatly enhancing electromigration lifetime (i.e. reliability under high current stress)research.ibm.com. These improvements stem from graphene’s ability to act as a conductive diffusion barrier, preventing metal atom migration and reducing scattering, thereby enabling faster and more durable chip wiring.
Reduced Contact Resistance and Better Interfaces: Graphene is also being explored as an ultra-thin interfacial layer in semiconductor packaging and devices to lower contact resistance. A 2024 study in the journal Electronics found that inserting a CVD-grown graphene sheet between metal and dielectric layers significantly decreased the contact resistance at the interfacemdpi.com. The graphene layer improved adhesion and stability of the metal-dielectric bond while maintaining excellent electrical contact. By integrating graphene at interfaces (for example, in advanced chip bonding or 3D stacking), researchers achieved more robust connections with measurably lower resistance, which can translate to faster signal propagation and reduced heat generation in integrated circuitsmdpi.com.
Thermal Management Improvements: Another critical semiconductor application is using graphene to enhance thermal interface materials (TIMs) for cooling electronics. Vertically aligned graphene structures have extremely high through-plane thermal conductivity, helping dissipate heat from chips. For instance, a 2024 study in Nano Research developed a graphene foam-based TIM that reached an out-of-plane thermal conductivity of ~48 W/m·K and very low contact resistance. In practical tests, this graphene-enhanced TIM achieved about 185% higher cooling efficiency compared to a standard commercial thermal padlink.springer.com. Likewise, aligned graphene TIMs have outperformed conventional materials like copper: one report showed a ~66% reduction in temperature (better cooling) versus a copper pad of similar size. These results illustrate how graphene’s superior heat conduction can keep semiconductor devices cooler, improving performance and reliability.
Allkemie has already worked with the Air force in a solution for CBRN suit. See the release below in the SBIR database.
"To address the Air ForceÆs need for advanced Chemical Warfare Agent (CWA) protection, Allkemie LLC proposes the development of a two-part Graphene CBRN Overgarment. This innovative protective suit integrates graphene materials to provide superior CBRN resistance and ballistic protection while significantly reducing weight and thermal load. The first part of the overgarment, a cloth-like graphene composite, offers enhanced maneuverability and comprehensive protection against CBRN agents. The second part consists of a graphene/polymer composite for ballistic protection, capable of meeting or exceeding Level III+ standards at a fraction of the weight of current solutions. This dual-layer approach ensures maximum protection and comfort for military personnel in hazardous environments, enhancing mission readiness and operational effectiveness."
Polymer/graphene nanocomposites for aerospace
A 2023 review in Carbon Trends covers graphene and GO reinforced composite materials used in aerospace structures—including epoxy, thermoplastics, and carbon fiber composites. Graphene oxide nanofillers were shown to boost tensile strength, fracture toughness, fatigue resistance, thermal stability, flame resistance, and even radiation shielding in aerospace-grade laminates (0.25–3 wt% loadings) MDPI+1.
Industrial CFRP laminates containing graphene-related materials
A 2020 experimental study demonstrated manufacturing aeronautical-grade carbon fiber composites with GO or rGO dispersed into an epoxy matrix via standard prepreg/autoclave processes. The resulting multiscale composites exhibited noticeable improvements in in‑plane shear strength, interlaminar shear strength (delamination resistance), flexural and tensile properties—without sacrificing producibility or quality arXiv.
Structural supercapacitor composite
A 2024 paper describes GO-based carbon fiber composites that serve both as load-bearing structural materials and as supercapacitors—maintaining ~99.6% capacitance retention under mechanical load, plus a tensile strength of ~139 MPa and modulus of ~8.6 GPa. While designed for energy storage integration, this architecture demonstrates that GO/carbon fiber composites can carry structural loads while sustaining functionality Springer+15.
Fuels Development
Fuel Additive
Normal Jet Fuel
Graphene-enhanced Jet Fuel
Allkemie has tested mixing Graphene Oxide with Jet Fuel and the results are an increase of 18% in Heat Power.
Antimicrobial textiles decorated with GO
A 2023 study in International Journal of Molecular Sciences compared textiles (e.g., cotton) decorated with graphene oxide and other carbon materials. GO-coated fabrics showed up to 98% inhibition of E. coli and S. aureus, and maintained ~90% effectiveness even after multiple washes. This aligns very closely with your in‑house coated‑fabric test scenario Nature+4.
GO coatings for sustained oral antimicrobial effect
Published in Scientific Reports (2022), this work developed GO/antimicrobial surfactant ultrathin films for dental surfaces. The GO layer self‑adhered even after rinsing and sustained antibacterial action against S. mutans and A. naeslundii for up to 7 days—demonstrating GO’s ability to retain active agents on a substrate surface over time PMC.
Antibacterial epoxy-coated aluminium surfaces with GO
An applied-materials study reported GO coatings on aluminum exhibiting strong antimicrobial activity—due to oxidative/nanoscale-mechanical mechanisms (membrane damage, ROS generation)—suggesting GO-coated metals or fabrics can be highly effective antimicrobial surfaces, potentially relevant for healthcare or clean-room settings MDPI.
Placed pieces of cloth in incubator for 48 hours:
Results:
Bacteria colonies in normal-fabric petri dish
No bacteria colonies in enhanced-fabric petri dish
Corrosion Resistance with Graphene Coatings: In the steel industry, a major focus has been using graphene-based coatings to protect against corrosion. Breakthrough research published in Small (2023) demonstrated that a high-quality graphene film grown by CVD can serve as an extraordinary anti-corrosion coating on mild steel. In 0.1 N NaCl saltwater tests, graphene-coated steel showed two orders of magnitude (≈100×) higher corrosion resistance than uncoated steelresearchgate.net. Impressively, the graphene layer maintained this protection over >1000 hours of continuous exposureresearchgate.net. Such graphene barriers are extremely impermeable to oxygen and moisture, explaining the dramatic reduction in rust formation. This finding showcases graphene’s potential to greatly extend the service life of steel structures (e.g. in construction or marine environments) by preventing oxidative degradation.
Graphene Oxide Enhancements in Alloys: Researchers have also incorporated graphene oxide into steel alloys and seen performance gains. A recent Scientific Reports study (2025) added 0.5–1.5 wt% GO powder to a low-nickel stainless steel via powder metallurgy and found markedly improved corrosion inhibition with increasing GO contentnature.com. Even at the microstructural level, the steel’s crystal structure remained largely unchanged by the GO, indicating the nano-additive can enhance surface chemistry (for corrosion resistance) without weakening the bulk metalnature.com. Importantly, that study also confirmed the GO-infused steel retained its biocompatibility (relevant for biomedical-grade stainless steel)nature.com. Beyond corrosion, graphene additions to metal matrices generally lead to strength and wear improvements: for example, small graphene inclusions in aluminum and nickel alloys have yielded ~20% increases in tensile strength along with better toughnesspmc.ncbi.nlm.nih.govresearchgate.net. Although integrating graphene directly into molten steel is challenging, these results highlight graphene’s role as a revolutionary nano-reinforcement – whether applied as a coating or as a dispersed phase – to produce stronger, more corrosion-resistant steels and metallurgical composites.
Graphene enhances polymers due to its extraordinary intrinsic properties and atomic-scale structure, which enable significant improvements in mechanical, thermal, and electrical performance.
Allkemie has improved the mechanical strength of Nylon (see pictures below comparing Nylon with and without Graphene in a nano indenter), making it 77% stronger and 137% harder. Kevlar and Nylon are not that different chemically speaking, a next step is to test if Kevlar can be equally improved.
Graphene presents an exciting opportunity to significantly enhance the properties of concrete, particularly in terms of durability and compressive strength. Research has consistently indicated graphene's potential to reinforce concrete structures, making them more resistant to cracking, chemical degradation, and environmental stresses. By introducing even small amounts of graphene, concrete can achieve notable improvements in its mechanical performance, potentially extending the lifespan of buildings and infrastructure. Recent studies (see table below from The Journal of Building Engineering) have highlighted that graphene-enhanced concrete exhibits increased compressive resistance, enabling stronger, more resilient construction materials. Our company has initiated preliminary tests incorporating graphene into cement formulations, achieving promising initial results that align with these research findings. We tested graphene in pure cement and increased its compressive strength by 24%, which translated into approximately 20% decrease in the cement needed in concrete (see below). These early-stage successes demonstrate graphene's potential as a transformative additive capable of setting new standards for concrete performance and sustainability in the construction industry.
